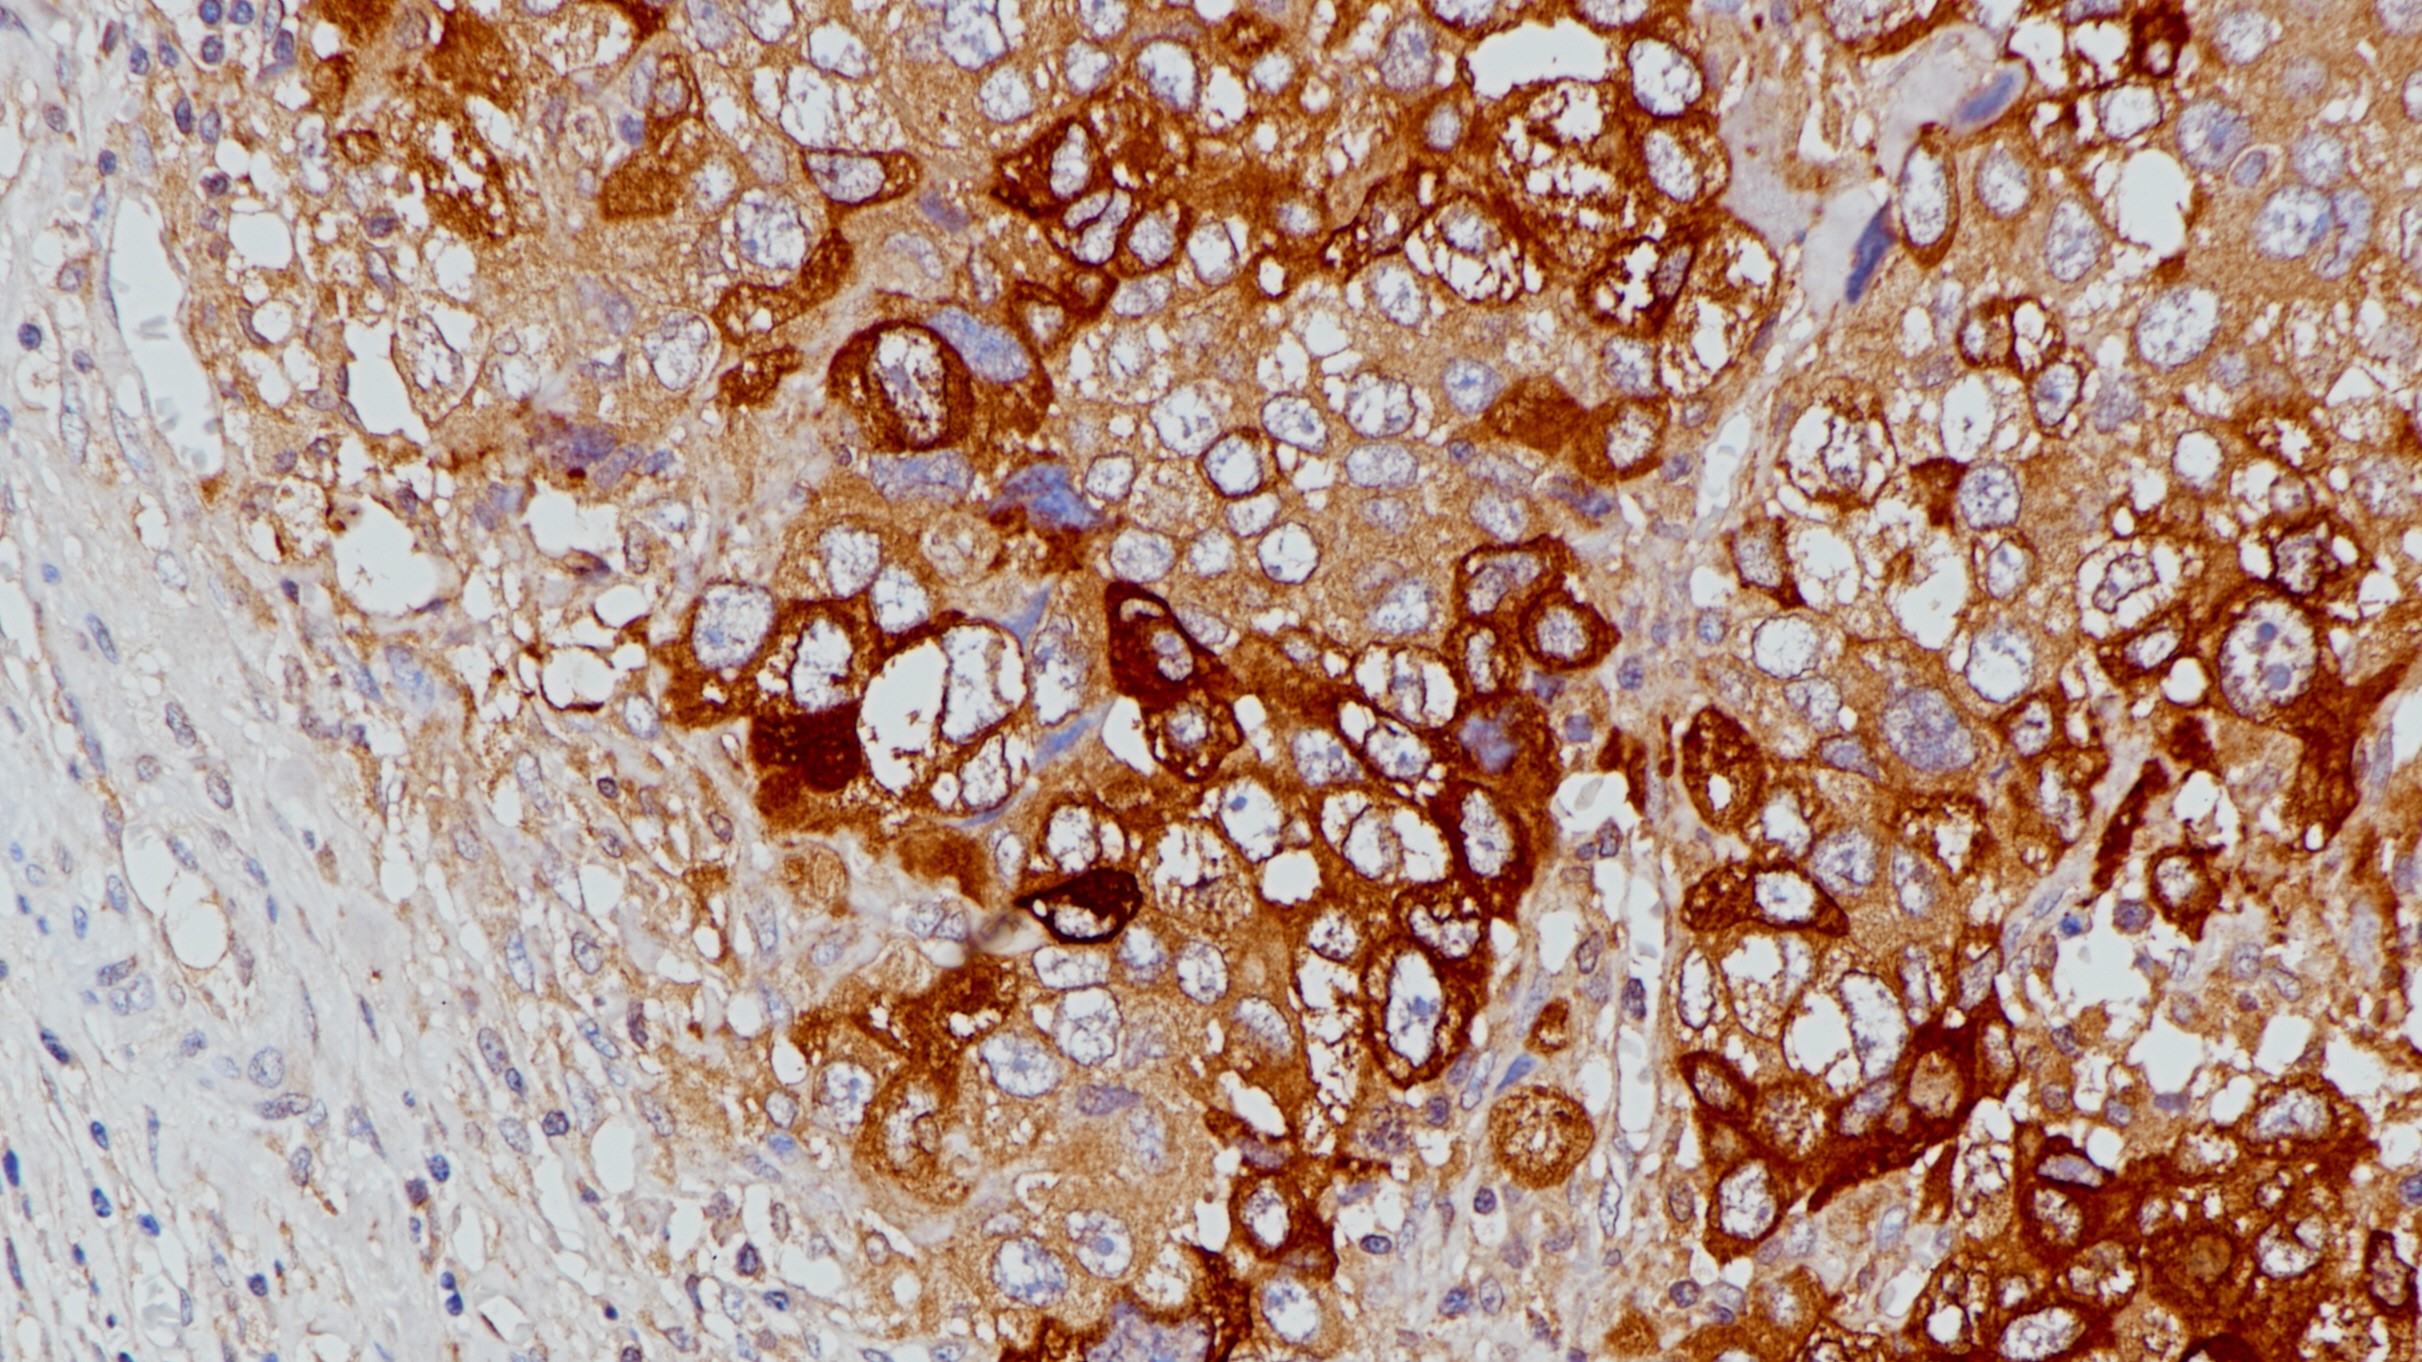

产品中心

胰腺Glucagon(BP6265)染色
Glucagon 重组兔单克隆抗体
胰高血糖素在葡萄糖代谢和体内平衡中起着关键作用。胰高血糖素通过增加糖异生和减少糖酵解来调节血糖。胰高血糖素是胰岛素的一种反调节激素,在胰岛素诱导的低血糖状态下升高血糖水平。它在糖尿病的启动和维持高血糖状态中起着重要作用。胰高血糖素在胰岛的A细胞和整个胃肠道的L细胞中分泌。胰高血糖素检测胰高血糖素分泌细胞和肿瘤,如胰高血糖素肿瘤。
Specifications
- 产品注册名称
- 胰高血糖素(Glucagon)抗体试剂
- 目录号
- I1255
- 克隆号
- BP6265
- 亚细胞定位
- 细胞质
- 阳性对照
- 胰腺
- 修复方式
- HIER
- 组织类型
- FFPE
- 规格
- 浓缩液:0.1mL/1mL 工作液:1.5mL/7mL
- 用途
- NMPA IVD
Applicable platform
- Biolynx平台
- Leica平台
- Roche平台
- Dako平台
Reference
1. 吴秉铨, 刘彦仿. 免疫组织化学病理诊断(第2版) [M]. 北京科学技术出版社, 2013.
2. 何建芳, 韩安家, 吴秋良. 实用免疫组化病理诊断[M]. 科学出版社, 2018.
3. Downes MA. Glucagon. Emerg Med (Fremantle). 2003 Oct-Dec;15(5-6):480-5.